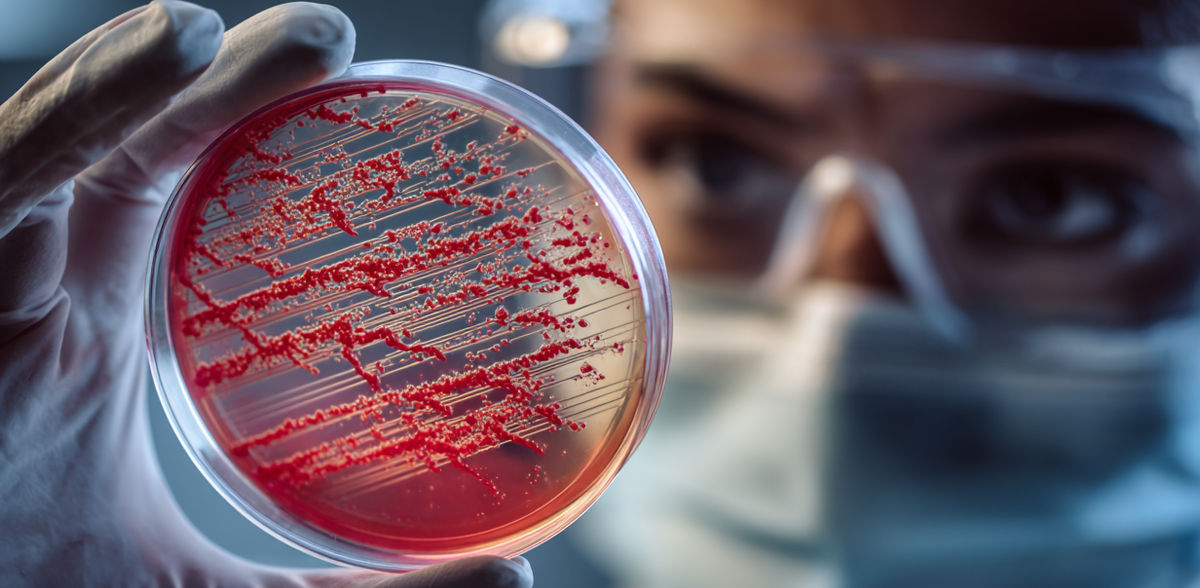
AI-generated image

Experimentelle mRNA-Therapie zeigt Potenzial zur Bekämpfung antibiotikaresistenter Infektionen
Lipid-Nanopartikel-Transportsystem enthält Anweisungen für antimikrobielle Peptikörper
Anzeigen
Forscher der Icahn School of Medicine am Mount Sinai und Mitarbeiter haben erste Erfolge mit einer neuartigen mRNA-basierten Therapie zur Bekämpfung antibiotikaresistenter Bakterien erzielt.
Die in Nature Biotechnology veröffentlichten Ergebnisse zeigen, dass die Therapie in präklinischen Studien an Mäusen und menschlichem Lungengewebe im Labor das Bakterienwachstum verlangsamt, die Aktivität der Immunzellen gestärkt und die Schädigung des Lungengewebes in Modellen für multiresistente Lungenentzündung verringert hat.
Antibiotikaresistente Infektionen stellen eine wachsende globale Bedrohung dar, an der jedes Jahr mehr als 1,2 Millionen Menschen sterben und die zu fast 5 Millionen Todesfällen weltweit beiträgt. Allein in den Vereinigten Staaten treten jährlich mehr als 3 Millionen Infektionen auf, die bis zu 48.000 Todesfälle verursachen und das Gesundheitswesen Milliarden von Dollar kosten. Experten warnen davor, dass die Resistenz bei fast allen wichtigen Bakterienarten zunimmt, wodurch Routineoperationen, Krebsbehandlungen und die Versorgung von Neugeborenen gefährdet sind.
"Unsere Arbeit deutet darauf hin, dass es einen neuen Weg geben könnte, antibiotikaresistente Infektionen durch eine direktere Unterstützung des Immunsystems zu bekämpfen", sagt Xucheng Hou, PhD, einer der Hauptautoren der Studie und Assistenzprofessor für Immunologie und Immuntherapie im Labor von Yizhou Dong, PhD , an der Icahn School of Medicine am Mount Sinai. "Obwohl wir uns noch im Anfangsstadium befinden und diesen Ansatz nur in präklinischen Modellen getestet haben, legen die Ergebnisse eine wichtige Grundlage für künftige Therapien, die die Wirkung herkömmlicher Antibiotika verbessern könnten."
Die experimentelle Therapie funktioniert, indem dem Patienten mRNA verabreicht wird, die den Körper anweist, ein spezielles Protein zur Infektionsbekämpfung, einen so genannten "Peptikörper", herzustellen. Dieser Peptibody soll an der Infektionsstelle zwei Dinge tun: schädliche Bakterien direkt abbauen und Immunzellen rekrutieren, die bei der Beseitigung der Bakterien helfen.
Um die mRNA sicher in den Körper des Patienten zu bringen, verpackten die Forscher sie in Lipid-Nanopartikel - winzige Bläschen auf Fettbasis, die üblicherweise in mRNA-Impfstoffen verwendet werden. Diese Nanopartikel schützen die mRNA auf ihrer Reise durch den Körper und helfen ihr, in die Zellen zu gelangen. Sie enthalten außerdem einen zusätzlichen Inhaltsstoff, der dazu beiträgt, schädliche Entzündungen einzudämmen, indem er überschüssige reaktive Sauerstoffspezies neutralisiert - hochreaktive Moleküle, die der Körper während einer Infektion produziert und die das Gewebe schädigen können, was oft zu den schweren Symptomen schwer zu behandelnder Infektionen beiträgt.
In Mausmodellen mit multiresistenten Staphylococcus aureus und Pseudomonas aeruginosa wurden wiederholte Gaben der Therapie gut vertragen, reduzierten die Bakterienzahl in der Lunge, verringerten die Entzündung und bewahrten die normale Lungenstruktur, berichten die Forscher. Darüber hinaus zeigten die Labortests mit menschlichem Lungengewebe ähnliche Ergebnisse, was beweist, dass die Therapie zusammen mit menschlichen Immunzellen wirken könnte.
Als Nächstes planen die Forscher, die präklinischen Studien fortzusetzen und schließlich klinische Studien am Menschen durchzuführen, um Sicherheit, Dosierung und Wirksamkeit zu untersuchen. Obwohl sich die Therapie noch in einem frühen Stadium befindet, stellt sie eine ermutigende Richtung im weltweiten Kampf gegen antibiotikaresistente Infektionen dar.
"Dies ist der erste Beweis dafür, dass ein mRNA-kodiertes antimikrobielles Peptid Bakterien direkt abtöten und gleichzeitig die Schutzreaktionen des Immunsystems aktivieren kann", sagt Dr. Dong, leitender Autor und Mitautor der Studie, Mount Sinai Professor für Nanomedizin und Mitglied des Icahn Genomics Institute und des Marc and Jennifer Lipzhultz Precision Immunology Institute (PrIISM) an der Icahn School of Medicine am Mount Sinai. "Wenn künftige Studien dies bestätigen, könnte dies die Tür zu einer äußerst anpassungsfähigen Plattform für die Entwicklung neuer Behandlungen gegen Infektionen öffnen, die auf die heutigen Antibiotika nicht mehr ansprechen."
Hinweis: Dieser Artikel wurde mit einem Computersystem ohne menschlichen Eingriff übersetzt. LUMITOS bietet diese automatischen Übersetzungen an, um eine größere Bandbreite an aktuellen Nachrichten zu präsentieren. Da dieser Artikel mit automatischer Übersetzung übersetzt wurde, ist es möglich, dass er Fehler im Vokabular, in der Syntax oder in der Grammatik enthält. Den ursprünglichen Artikel in Englisch finden Sie hier.
Originalveröffentlichung
Yonger Xue, Xucheng Hou, Siyu Wang, Yuebao Zhang, Yichen Zhong, Diana D. Kang, Chang Wang, Haoyuan Li, Changyue Yu, Zhengwei Liu, Meng Tian, Dinglingge Cao, Ya Ying Zheng, Binbin Deng, Pauline Hamon, Miriam Merad, Yizhou Dong; "Antimicrobial peptide delivery to lung as peptibody mRNA in anti-inflammatory lipids treats multidrug-resistant bacterial pneumonia"; Nature Biotechnology, 2025-11-26